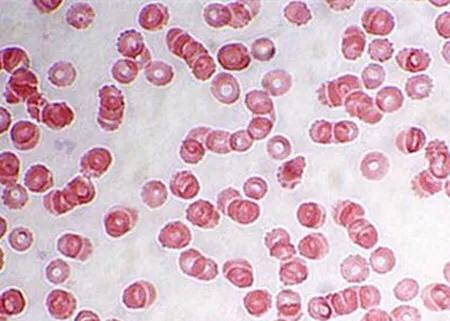
白细胞低医生说要做穿刺来检查,感冒发烧查血常规发现白细胞低
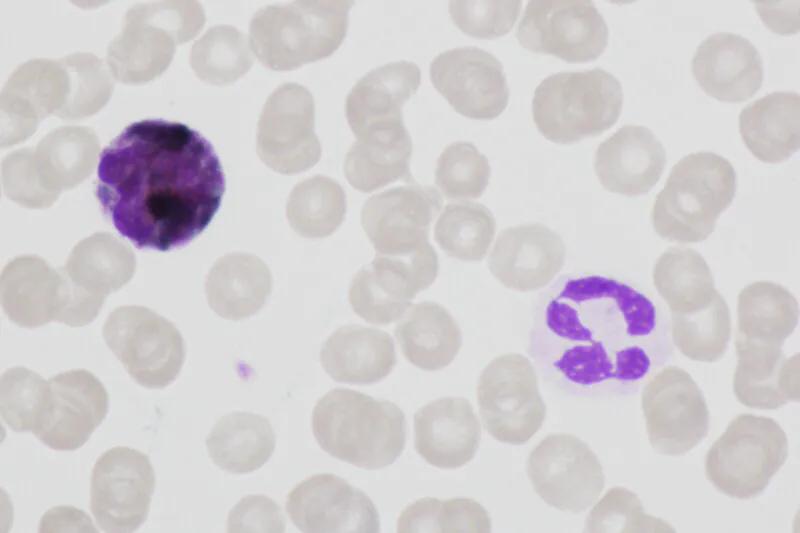
白细胞低医生说要做穿刺来检查,感冒发烧查血常规发现白细胞低

去医院看病,难免要做一些检查,最常做的检查是血常规。

通过血常规,可以了解是不是有贫血,有没有血小板减少,更重要的是看看白细胞的数量和构成比例。
有一位35岁的女性,乙肝病毒携带者,没有肝炎发作,每隔三个月定期复查一次。
但最近患者偶尔查个血常规,发现白细胞减少,只有3400,自觉比较累,肝功能、B超等检查并没有什么问题,没有引起白细胞减少的肝病因素(主要是肝硬化引起的脾功能亢进)
患者前段时间有过一次短暂的“感冒”,表现为发热、头痛、打喷嚏、流鼻涕,过几天就好了。

白细胞减少在临床上不少见,除了病毒感染性的疾病如“感冒”,肝硬化、伤寒、化疗后、打干扰素等药物后,等等情况下,都可能出现白细胞减少。
今天,龙大夫就来谈谈白细胞低的问题。
需要提醒大家的是,有一些白细胞减少可能是血液系统的疾病,这个需要血液科的专科医生诊治,不属于本文讨论的范围。
白细胞低,是指外周血白细胞计数少于4000/μL(即4.0×10∧9/L, 下同),现在很多医院的血常规参考值不一致,那就以低于报告单上的参考值下限,作为判断的依据。
白细胞计数,是包括淋巴细胞等在内的一系列白细胞的总数。
淋巴细胞、单核细胞、嗜酸性或嗜碱性粒胞等对白细胞总数有影响,但由于中性粒细胞占绝大多数,其计数值通常是由中性粒细胞数量减少引起的。
通常所说的白细胞低,多指中性粒细胞减少。

中性粒细胞减少,是指外周血中性粒细胞数量低于1500/μL,如果同时伴有单核细胞和淋巴细胞减少,比单独白细胞减少更为严重。
中性粒细胞减少明显,甚至低于1000/μL,会使患者对细菌和真菌的抵抗力明显下降,容易感染,因为中性粒细胞是人体抵御细菌和真菌感染的主要防线。
中性粒细胞低于500/μL时,称为中性粒细胞缺乏,容易引发严重感染,如败血症和脓毒血症,这种情况表示病原体不断在局部感染,还跑到血液里面兴风作浪去了。

- 中性粒细胞减少时
机体对感染的炎症反应也降低,比如一些老年人、体弱者或儿童,严重感染时,甚至不出现发热,表现为体温过低,就和炎症防御反应失效有一定的关系。

- 中性粒细胞缺乏时
人体口腔、管道、皮肤表现的一些平常不致病的常居菌(又叫正常菌群),也能趁机大量繁殖,侵入不常寄居的部位,引起感染,叫做机会性感染。
- 低于200/μL的急性、严重的中性粒细胞减少
在合并其他减弱人体免疫力的因素的情况下,如癌症时,能够造成快速、致命性的感染,要特别引起重视。
中性粒细胞低,在人体皮肤和黏膜完整性遭到破坏、营养不良的情况下,对感染也有很大的影响。
严重中性粒细胞减少,最常见的化脓性感染是:蜂窝组织炎、肝脓肿、疖病、肺炎和败血症等。

临床上,发现白细胞减少后,要根据具体的情况,作进一步的处理和决策:
- 1、感染风险的评估
首先,需确定是否有感染存在
对最常发生感染的部位,进行系统的体格检查,包括皮肤、指甲、黏膜表面(牙龈、咽部等)、尿道口、肺部、腹部、静脉穿刺点等。
其次,要做检查确定感染部位
伴有发热的白细胞减少患者,最好行血培养检查;
怀疑尿路或肺部感染,需要做尿、痰液培养;
如果腹泻,粪的病原学检查也很重要的;
反复的发热和白细胞减少,可能需要骨髓穿刺涂片和培养等检查,以进一步明确病因。

- 2、临床相关的治疗
怀疑感染存在急性中性粒细胞减少,需要立即进行治疗。
如有发热,伴血压低,提示病情严重,需要根据医生的临床经验予大剂量抗生素治疗,同时补充液体,以纠正感染引起的血容量不足或休克。
为防止白细胞减少引发的机会感染,需要注意皮肤和黏膜的卫生,特别是口腔卫生。
建议每隔2-3小时用生理盐水或过氧化氢漱口液漱口一次,可减少由口腔黏膜侵入的细菌、真菌感染。
对于食欲不振者,应予流质或半流质饮食,注意维生素的摄入和蛋白质的补充;如增加鸡蛋、瘦肉、鱼肉、牛奶的摄入,多吃蔬菜、水果。
- 3、粒细胞生长因子
粒细胞-巨噬细胞集落刺激因子目前已经广泛应用于严重的中性粒细胞减少症患者,以增加中性粒细胞生成和预防感染,需在医生指导下使用。
- 4.日常保健措施
没有症状的单纯轻度白细胞减少,如果没有淋巴结肿大、脾肿大等表现,不一定要用升白细胞的药物。

平时的饮食中,如果缺乏维生素B12、叶酸、铜等,也可能会导致中性粒细胞减少,可以多吃绿叶蔬菜、谷物、豆类、瘦肉、肝、鱼肉和禽肉等,育龄期女性建议按要求补充叶酸。

感谢阅读,如果文章对您有用,请点赞、评论、留言、赞赏!
如果对作者感兴趣,欢迎点击右上角关注!
#清风计划# #青云计划# #我的门诊故事#